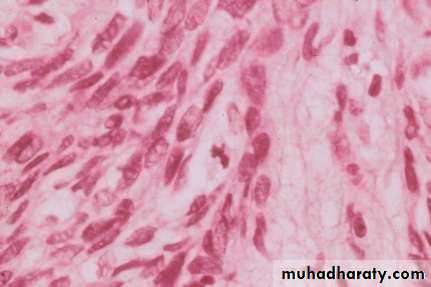

• Odontogenic tumor
• Copyright 2003, Elsevier Science (USA). All rights reserved.
• Introduction
• The most common neoplasm of the jaws is odontogenic and it is unique to the jaws.
yright 2003, Elsevier Science (USA). All rights reserved.
• Classification
• Benign epithelial Odontogenic T• ameloblastoma
• Adenomatoid odontogenicT
• Squamous odontogenic T
• Calcifing odontogenic T
• Benign Mixed odontogenic T
• Ameloblastic Fibroma
• Ameloblastic Fibrodintinoma
• Ameloblastic fibro-odontoma
• Odonto ameloblastoma
• Benign mesenchymal odontogenic T
• odontogenic fibroma
• Odontogenic myxoma
• Cemento blastoma.
• Hamartomas
• Odontomas
• Compound odontomas
• Complex odontomas
• Malignant epithelial Tumor.
• Odontogenic carcinoma
• Malignant mesenchymal tumor
• Odontogenic Sarcoma.
• Cop
• Ameloblastoma
• Is a benign locally aggressive odontogenic tumor arises from odontogenic epithelium• Enamel organ
• The cause unknown
• Copyright 2003, Elsevier Science (USA). All rights reserved.
• Ameloblastoma
• Clinical feature :• The most common
• 30-40 years
• Male.
• Rare in children .
• 80% in mandible
• 70% in posterior region ( Ramus ) 2o% premolar 10% incisor .
• Usually asymptomatic .
• Slow grow expansion of the jaw cortical bone produce shell bone
•
• Copyright 2003, Elsevier Science (USA). All rights reserved.
• Copyright 2003, Elsevier Science (USA). All rights reserved.
• Egg shell cracking .
• Pain , paresthesia, mobility of regional teeth .• Pathological fracture .
• The overlying mucosa normal
• Maxillary lesion may produces pressure effect and nasal obstruction
• Copyright 2003, Elsevier Science (USA). All rights reserved.
• Ameloblastoma
• Radiography:• Uni or Multilocular radiolucent areas
• Soap bubbles
• Copyright 2003, Elsevier Science (USA). All rights reserved.• Ameloblastoma
• Radiography:
• Soap bubbles appearance
• Copyright 2003, Elsevier Science (USA). All rights reserved.• Ameloblastoma
• Histopathology:
• Usually there are many histological• Variants of ameloblastoma.
• 1. Follicular ameloblastoma.
• Islands or trabeculae of epithelial cells
• in a connective tissue stroma
• Ameloblast-like cells" which have " reversed polarity“
• These pattern of growth resembling the early stages of tooth development
• Core of loosely arranged polyhedral or angular cells resembling satellite reticulum
• Copy1righ.t 2003, Elsevier Science (USA). All rights reserved.
• Variants of ameloblastoma.
• 2. Plexiform ameloblastoma:
• Arranged in a network or anastomosing strands• 3. acanthomatous amploblastoma.
• central core of the neoplastic epithelium shows squamous metaplasia
• Plexiform
• acanthotic• Copyright 2003, Elsevier Science (USA). All rights reserved.
• Variants of ameloblastoma.
• 4. Basal cell ameloblastoma.
• Trabecular pattern of growth with little evidence of palisading at the periphery. They have been mistakes with basal cell carcinoma• 5. Granular cell ameloblastoma.
• 6. Desmoplastic ameloblastoma:
• Copyright 2003, Elsevier Science (USA). All rights reserved.
• 7. Flexiform unicystic ameloblastoma: Children between 10-19 years Typically in the mandible .
• 80% ,the cyst enclose the crown of impacted .
• severely displaced mandibular 3rd
• molar
• Unilocular radio-lucency
• Copyright 2003, Elsevier Science (USA). All rights reserved.
• Variants of ameloblastoma.
• 8. Peripheral ameloblastoma.
• These tumors are extraosseous and therefore occupy the lamina propria underneath the surface epithelium but outside of the bone.• Histologically, these lesions have the same features as the intraosseous forms of the tumor
• Patients respond well to local surgical excision.
• Copyright 2003, Elsevier Science (USA). All rights reserved.
• Ameloblastoma.
• Ameloblastoma is locally aggressive tumor and may extened to the bone or surrounding soft tissue• Treatment:
• Enaculation with thorough bone curettage .• Radical surgical approch
• Copyright 2003, Elsevier Science (USA). All rights reserved.
• Adenomatoid tumor
• Uncommon benign tumor, originated from reduced enamel epithelium of post secretory phase of enamel development• REE
• 3-7% of all odontogenic tumors• Copyright 2003, Elsevier Science (USA). All rights reserved.
• Adenomatoid tumor
• Clinical feature :• Associated with an impacted.
• Asymptomatic
• Late adolescent or young adulthood .
• Female .
• 65% in the maxilla
• 75% associated with impacted
• teeth
• Small slow growing mass on the anterior maxilla, rarely premolar
• Cause an elevation of the upper lip.
• Pain and tooth placement.
• Rarely extra-osseous (Gingival)
• Radiolucent area surrounding impacted tooth
• Copyright 2003, Elsevier Science (USA). All rights reserved.
• Adenomatoid tumor
• Radiography:
• AOTs typically appear as• pericoronal radiolucencies, which may have radiopaque material (“snowflake” calcifications) within the lucency
• Copyright 2003, Elsevier Science (USA). All rights reserved.
• Copyright 2003, Elsevier Science (USA). All rights reserved.
• Adenomatoid tumor
• Histopathology:• Sheets or islands of epithelial cells arrange around microcyst ( Ducts or ductules ) .
• Surrounded by thin vascularized stroma .
• The ductules bordered by ameloblast like cells .
• The lumen filled by homogenous
• eosinophilic material .
• Small foci of calcification .
• Copyright 2003, Elsevier Science (USA). All rights reserved.
• Calcifying epithelial odontogenic tumor
• Benign , locally aggressive tumor originated from the rest of dental lamina and/or REE .• " Bindborg" tumor.
• Rare tumor ( Less than 1%)
• ,could be mistaken with poorly differentiated squamous cell carcinoma
• Copyright 2003, Elsevier Science (USA). All rights reserved.
• Calcifying epithelial odontogenic tumor
• Clinically :• Affect adult ,40 years.
• More common in the mandible
• Molar and premolar region
• crown of the unerupted teeth.
• Either central or peripheral
• Intraosseous lesion mainly produce slowly growing painless mass at the mandible.
• Nasal obstruction, epistaxis are some time present in the maxillary lesion.
• Peripheral ( Extraosseous) is most commonly present in the anterior part of the mouth .
• Copyright 2003, Elsevier Science (USA). All rights reserved.
• Calcifying epithelial odontogenic tumor
• Radiograph:
• The lesion appears as radiolucent area with poorly defined margin with fine flecks of radio-opacities (due to calcification).• Impacted tooth and flicks of calcification
• Copyright 2003, Elsevier Science (USA). All rights reserved.• Calcifying epithelial odontogenic tumor
• Histopathology:• Sheets or strands of epithelial cells
• Cells are polyhedral exhibit pleomorphism, including multinucleated giant .
• Stroma lacks of inflammatory infiltrate
• Pools of homogenous eosinophilic material seen within and between the epithelial sheets with spherical calcification
• Copyright 2003, Elsevier Science (USA). All rights reserved.
• Treatment:
• Conservative local resection is the treatment of choice as these lesions are typically less aggressive than the ameloblastoma.• With this treatment the recurrence rate is approximately 15 % and the overall prognosis is good
• Copyright 2003, Elsevier Science (USA). All rights reserved.
• Squamous odontogenic tumor
• Rare tumour, believed to be arise from neoplastic transformation of rest of malassiz• Rest of malassiz
• Copyright 2003, Elsevier Science (USA). All rights reserved.• Squamous odontogenic tumor
• Clinical feature:• Affect the patient 2nd -7th decade ( Mean age 40).
• Occur in mandible and maxilla in
• equal frequency.
• Typically involve the alveolar process anterior to the molars of either jaws. Close to the roots of erupted tooth.
• Painless swelling or as loosening of teeth
• Copyright 2003, Elsevier Science (USA). All rights reserved.
• Squamous odontogenic tumor
• Appear as non-specific radiolucent lesions. They may be well-circumscribed or ill- defined. They often appear triangular in shape and lateral• to the tooth root.
• Some time mimic sever bone loss from periodontitis.
• Copyright 2003, Elsevier Science (USA). All rights reserved.
• Copyright 2003, Elsevier Science (USA). All rights reserved.
• Squamous odontogenic tumors
• Histologically, they appear as islands of bland-appearing well differentiated squamous epithelium in a mature fibrous connective tissue stroma.
• The peripheral cells flattening do not show the characteristic polarization seen in the ameloblastoma
• Treatment:
• Conservative local excision or curettage appears to be effective treatment and there have only be a few recurrences reported• Ameloblastic fibroma
• Rare biphasic tumor, because the epithelial and mesendymal components are part of• the neoplastic process.
• Resembles dental papillae
• Copyright 2003, Elsevier Science (USA). All rights reserved.
• Clinical feature:
• Young adult and children.• 70% in mandible
• frequently located at mandibular molar area, often over an unerupted tooth
• Copyright 2003, Elsevier Science (USA). All rights reserved.
• Radiography:
• Generally, these lesions appear as either a unilocular or multilocular radiolucency.• They tend to be well-defined and may have a sclerotic border.
• Approximately, 50 % are associated with an unerupted toot
• Copyright 2003, Elsevier Science (USA). All rights reserved.
• Odontogenic fibroma
• Histopathology :• Microscopically characterize by thin strand and cords of odontogenic epithelium that resemble dental lamina at the cap and bell stages of early odontogenesis.
• The background compose of loose but cellular fibromyxoid connective tissue wildly separated by fibroblast, which resemble the immature dental papillae.
• Copyright 2003, Elsevier Science (USA). All rights reserved.
• Ameloblastic fibro-odontomas
• In these pathological entity cells in one or more foci continue the differentiation process and produce enamel, dentin and cementum in the• form of compound or
• complex
• Copyright 2003, Elsevier Science (USA). All rights reserved.
• Ameloblastic fibro-odontomas
e
• Most common in the 5-12 year ag
• More common in the premolar/molar regions of both jaws.
• Radiographic Features: Usually appears as a well-defined unilocular or rarely multilocular radiolucency with variable amounts of calcified material which is radiopaque. Therefore, it may appear as a
• mixed, radiolucent-radiopaque lesion.
• Copyright 2003, Elsevier Science (USA). All rights reserved.
• Ameloblastic fibro-odontoma
• Histopathology :• Identical to the ameloblastic fibroma. The calcified portion consists of foci of enamel and dentin matrix formation in close relationship to the epithelial structures.
Dentin
• The ameloblastic fibro-odontoma is usually treated by conservative curettage .• Prognosis is excellent and recurrence is unusual
• Copyright 2003, Elsevier Science (USA). All rights reserved.
• Odontogenic fibroma
• Benign neoplasm derived from connective tissue of odontogenic origin containing widely scattered islands and strands of embryonic• odontogenic epithelium and
• calcification.
Two types:
• Central ( Intraosseous) WHO type odontogenic fibroma .• Peripheral odontogenic fibroma .
• Peripheral odontomas
• Copyright 2003, Elsevier Science (USA). All rights reserved.• Odontogenic fibroma
• Uncommon• Patient age ranged from 9-80 years old with a mean of 40 years.
• More common in Female
• 60 % in the maxilla ,anterior to the first molar.
• In the mandible, 50 % occur in the posterior jaw.
• Small lesion usually asymptomatic.
• The larger associated with localized bony expansion or with the loosening of adjacent teeth
• Copyright 2003, Elsevier Science (USA). All rights reserved.
• Odontogenic fibroma.
• Histopathology:• The WHO type odontogenic fibroma appears as a fairly cellular fibrous connective tissue with collagen fibers arranged in interlacing bundles.
• Odontogenic epithelium in the form of long strands or isolated nests is present throughout the lesion.
• Calcifications composed of cementoid and/or dentinoid may be present.
• Copyright 2003, Elsevier Science (USA). All rights reserved.
• Odontogenic myxoma
• Locally aggressive intraosseous lesion derived from dental mesenchymal tissue, resembling microscopically the dental pulp or follicular• connective tissue.
• Dental papilla
• Copyright 2003, Elsevier Science (USA). All rights reserved.• Odontogenic myxoma
• Clinical feature :• Young people without sex predilection.
• More common in the mandible
• Mandibular lesion found in molar and premolar areas often extended into ramus.
• Maxillary lesion erode into sinus
• Most lesion are show growing painless, fusiform swelling that some time displace teeth
• Copyright 2003, Elsevier Science (USA). All rights reserved.
• Odontogenic myxoma
• Histopathology:• The tumor is composed of loosely arranged stellate, spindle-shaped and round cells in an abundant, loose myxoid stroma with few collagen bundles.
• Myxoma
• Copyright 2003, Elsevier Science (USA). All rights reserved.• Odontogenic myxoma
• Radiography:• Typically appears as multi locular radiolucent area with well defined scalloped margin or soap bubble.
• Copyright 2003, Elsevier Science (USA). All rights reserved.
• Odontogenic myxoma
• Treatment :• Small odontogenic myxomas are treated by curettage, while larger lesions may require surgical resection.
• Odontogenic myxomas are not encapsulated and tend to infiltrate adjacent tissues.
• Recurrence rates of up to 25 % are reported.
• Overall, the prognosis is good for most odontogenic myxomas.
• Copyright 2003, Elsevier Science (USA). All rights reserved.
• Cementoblastoma
• Benign neoplasm of the cementoblastic origin compose of cementum like tissue growing in continuity with apical cemental layer of• molar and premolar that
• produce expansion of cortical bone and pain.
• Cementoblastoma
• Copyright 2003, Elsevier Science (USA). All rights reserved.• Cementoblastoma
• Clinical feature:• 2nd and 3rd decade.
• Comentoblastoma forms an irregular or rounded mass attached to the apical ⅓ of the roots.
• They are slow growing and the jaw
• is not usually expanded
• Pain is diagnostic feature , usually of low grade intermittent pain and become more intense when the area is palpated.
• The tooth is vital
• More often seen in mandible than the maxilla .
• Copyright 2003, Elsevier Science (USA). All rights reserved.
• Cementoblastoma
• Radiography:• Typically appears as radio opaque rounded mass with thin radiolucent margin.
• Attached to the root.
• Resorption of the related root is common.
• Cementoblastoma
• Copyright 2003, Elsevier Science (USA). All rights reserved.• Cementoblastoma
• Histopathology:
• Conglomerate of cementum which often contain reversal line and cells are enclosed in lacunae.• Peripheral zone has unmine ralized tissue while the center more mineralized .
• Intervening soft tissue is loose very cellular and vascularized, contain multinucleated cementoclast and cementoblast.
• Reversal lines
• Copyright 2003, Elsevier Science (USA). All rights reserved.• Odontomas
• Odontomas are developmental malformation ( hamartoma) of dental tissue, it is not neoplasim• 1. Compound: Composed of
• multiple small tooth-like• structures.
• 2. Complex: composed of a conglomerate mass of enamel and dentin, which bears no anatomic resemblance to a tooth
• Compound
• Complex
• Copyright 2003, Elsevier Science (USA). All rights reserved.• Odontomas
• Clinical feature :• 70% of odontogenic tumor .
• More common in the maxilla.
• The compound type is more often in the anterior maxilla .
• complex type occurs more often in the posterior regions of either jaw.
• Most odontomas are small and do not exceed the size of a normal tooth in the region.
• Copyright 2003, Elsevier Science (USA). All rights reserved.
• Odontomas
• Large lesion cause expansion of the jaw.• Most odontomas are asymptomatic.
• Odontomas may block the eruption of a permanent tooth .
• Erupted odontomas
• Copyright 2003, Elsevier Science (USA). All rights reserved.• Odontomas
• Compound Complex
• The compound type shows apparent tooth shapes while the complex type appears as uniform opaque mass with no apparent tooth shapes present• Copyright 2003, Elsevier Science (USA). All rights reserved.
• Odontomas
• Histopathology:• The compound odontoma is composed of enamel, dentin and cementum arrange in recognizable tooth forms; some enamel matrix may be retained in immature and hypomineralized specimens.
• The complex odontoma is composed of enamel, dentin and cementum but these tissues are arranged in a random manner that bears no morphological resemblance to a tooth.
• Compound
• Copyright 2003, Elsevier Science (USA). All rights reserved.• Complex
• Malignant Ameloblastoma and Ameloblastic Carcinoma
• Less than 1 % of the ameloblastomas show malignant behavior with the development of metastases.• Malignant ameloblastoma is a tumor that shows histologic features of the typical (benign) ameloblastoma in both the primary and secondary deposits.
• Ameloblastic carcinoma is a tumor that shows cytologic features of malignancy in the primary tumor, in recurrence and any metastases
• Carcinoma
• Copyright 2003, Elsevier Science (USA). All rights reserved.• Ameloblastic fibrosarcoma
• Malignant counterpart of the ameloblastic fibroma in which the mesenchymal portion shows features of• malignancy.
• The ameloblastic fibrosarcoma may arise as malignant transformation of an ameloblastic fibroma
• Copyright 2003, Elsevier Science (USA). All rights reserved.
• Ameloblastic fibrosarcoma
• Histopathology:• The epithelial component histologically benign.
• The mesenchymal portion is highly cellular. The cells are hyperchromatic and quite pleomorphic. Mitoses are usually prominent
• Mitosis